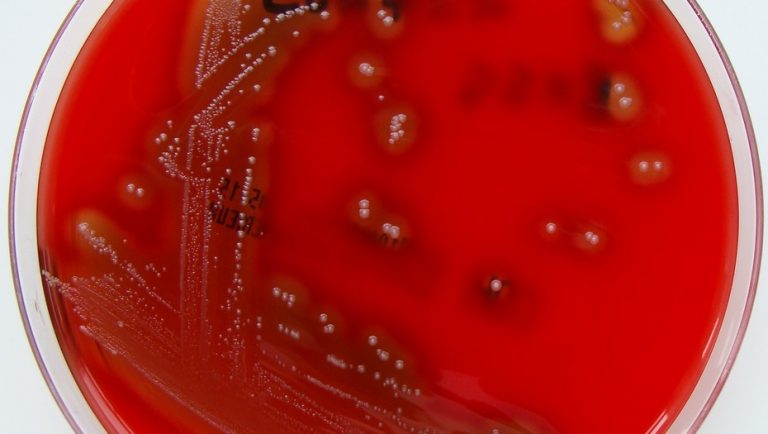

Informe del Consejo de Políticas Sociales. Pases de Provincia para retirar
Informe del Consejo Municipal de Políticas Sociales Atención: Pases libre de Provincia para retirar 1- López, Martina. 2- Vázquez, José Raúl. 3- Tolosa, Antonio Manuel. 4- Lettiere Pereyra, Valentina. 5- Santana. Edgardo Nahuel. 6- Gaspar, Pablo Daniel. 7 -Rosendi, Rubén Miguel. Horario de 7 hs. a 13 y 30 hs.